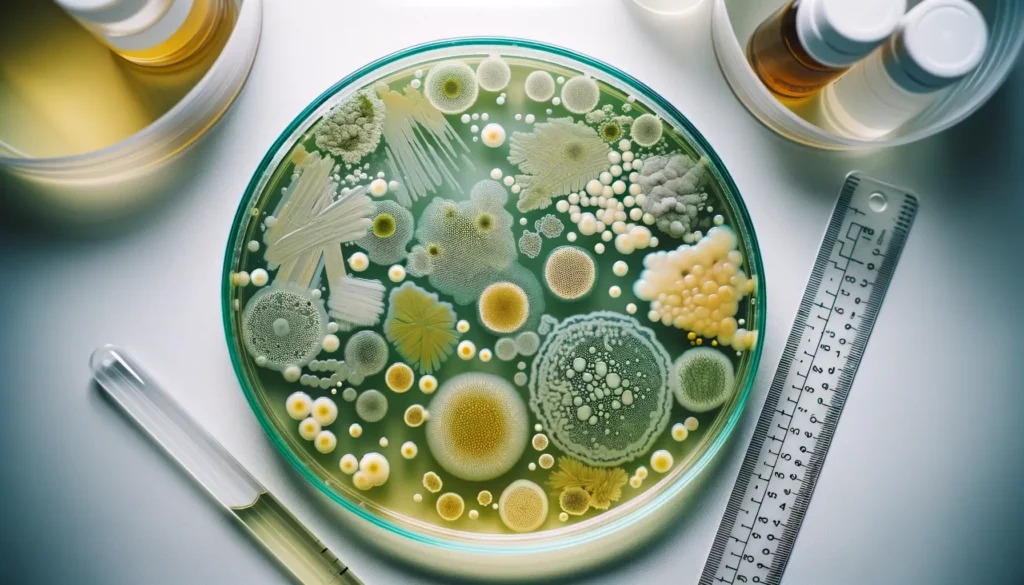
Photo of a petri dish viewed from above, containing stagnant water with various stages of bacteria growth, with visible colonies in shades of green, yellow, and white. The colonies are irregularly shaped and densely packed in some areas, while more scattered in others, against a translucent, slightly murky water background. The dish is placed on a white lab table with a clear ruler beside it for scale, under bright laboratory lighting.

Ever taken a deep breath only to be hit by a stench reminiscent of a stagnant swamp? If that’s coming from your bong, we’ve got a problem. Your smoking experience is sacred, and the purity of your glass bong plays a pivotal role. So, let’s dive into the high tide of maintaining a pristine water pipe, answer the burning question: “How often should you clean your bong?”, and discover where to snag the finest clear glass bongs.
The Time is Now: Regular Bong Maintenance
How often should you clean your bong? Well, if your bong could talk, it’d beg for a rinse after every use! Realistically, a daily scrub might be overkill, but leaving it dirty is a party invitation for bacteria. Aim to clean your glass piece after every one to two uses to avoid resin buildup, maintain a fresh taste, and steer clear of potential lung infections.
Every Session’s Silent Guest: Bacteria
Why stress over a clean bong? Picture this: your dirty bong water is a breeding ground for microbes partying like it’s 1999. Old water becomes a petri dish, teeming with germs that could lead to a real lung buster (and not the good kind). Your health isn’t a joke; switch out your bong water frequently and scrub away the unwanted guests.
When Water Becomes the Enemy
Fresh water is crucial. Heavy smokers should adhere to a 24-hour rule—old bong water transforms from cool to cruel quickly. Each session should begin with clean water, ensuring that every inhale is crisp and contaminant-free.
The Glass Menagerie: Best Spots for Quality Bongs
So where to buy a clear glass bong that won’t disappoint? Here’s a treasure map to the X marks the spot. And if you’re eager to see the selection, shop clear glass bongs directly at our shop.
The Ritual: Cleaning Your Sacred Smoke Vessel
What’s the deal with regular cleaning? It extends your bong’s life, keeps your smoke pure, and let’s face it—it’s a nod to the respect you have for the ritual. Gather your coarse salt, isopropyl alcohol, and get ready to work some magic.
A Step-by-Step Guide to Sparkling Glass
- Empty old bong water—no brainer, right?
- Add isopropyl alcohol and coarse salt—the dynamic duo for crud destruction.
- Shake like you’re mixing a cocktail for the gods.
- Rinse with hot water—watch the resin disappear.
- Repeat if needed; sometimes the grime is stubborn.
The Tools: What You Need for a Gleaming Bong
- Isopropyl alcohol (91% works wonders)
- Coarse salt (your scrubbing agent)
- Pipe cleaners or a brush (for those hard-to-reach spots)
- Paper towels (for drying and polishing)
FAQs: Your Bong Cleaning Curiosities Answered
“What happens if you don’t wash your bong?” It becomes a vile concoction of tar and bacteria. Imagine smoking your favorite blend through a musty cellar.
“Is it important to keep your bong clean?” Absolutely! Unless you’re a fan of hacking up something fierce, keep it clean.
“Should you clean a bong after every use?” Ideal? Yes. Necessary? Not quite, but don’t wait too long!
“How do you dispose of bong water?” Safely pour it down the drain, and maybe light a candle for the olfactory sake of your bathroom.
“Is bong water good for anything?” As fertilizer, perhaps, but your plants might not appreciate the THC content.
Visualize Your Clean: The Why and the Way
Remember, a visual of your bong’s cleanliness routine isn’t just neat—it’s necessary. A quick glimpse at a chart or a before-and-after image can boost your understanding and motivate maintenance. Don’t let your bong’s beauty be overshadowed by neglect.
3 Compelling Reasons to Keep Your Bong Sparkling
- Better Taste: Your blend deserves the cleanest canvas for its palette of flavors.
- Healthier Hits: Keep those lung infections at bay with a pristine piece.
- Aesthetic Pride: A clear glass bong is a piece of art—treat it as such.
Wrap Up: A Clean Bong is a Happy Bong
Remember, how often should you clean your bong? The answer is simple: as often as needed to ensure a pure, pleasurable smoking experience.


































